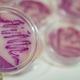

Na območju Murske Sobote, Raven na Koroškem, Celja in Ljubljane so v zadnjih dneh našteli devetnajst okužb z bakterijo salmonele. Enajst ljudi je imelo tako hude prebavne motnje, da so …
Dnevnik · 3L

Sanja Vuzem z Nacionalnega inštituta za javno zdravje (NIJZ) je v današnji izjavi za medije spomnila, da so bile regijske epidemiološke službe v začetku tedna obveščene o kopičenju primerov salmonelioz …
Koroške novice · 3L

Pri povečanem številu primerov salmoneloze v zadnjih dneh, pretežno na območju Murske Sobote, Raven na Koroškem in Celja, je najresnejši vir okužbe na podlagi dosedanjih analiz uživanje tatarskega biftka v …
Reporter · 3L

Pri povečanem številu primerov salmoneloze v zadnjih dneh, pretežno na območju Murske Sobote, Raven na Koroškem in Celja, je najresnejši vir okužbe na podlagi dosedanjih analiz uživanje tatarskega biftka v …
Primorske novice · 3L

Do današnjega dne so skupno odkrili salmonelo pri 19 osebah. Analize še potekajo, a obolelim je skupno, da so vsi uživali Fingušt tatarski biftek proizvajalca Mesnine Štajerske. V preteklih dneh …
Večer · 3L
Pri povečanem številu primerov salmoneloze v zadnjih dneh, pretežno na območju Murske Sobote, Raven na Koroškem in Celja, je najresnejši vir okužbe na podlagi dosedanjih analiz uživanje tatarskega biftka v …
Regional · 3L
nadja škrkbranko podpečantatarski bifteknijzsalmonelasanja vuzem

Primeri so se nenadoma pojavili v več regijah. Izkazalo se je, da primeri večinoma niso povezani med seboj sorodstveno ali prek skupnih dogodkov. S tem je bil nakazan skupni izvor …
Metropolitan.si · 3L

Hospitaliziranih je bilo 11 bolnikov, ostali so bili obravnavali ambulantno ali v dnevnih bolnišnicah. Večina je bila že odpuščena, le še dve osebi naj bi bili v bolnišnici. Pri povečanem …
Večer · 3L

Znane so podrobnosti večjega števila okužb na vzhodu države. Uprava za varno hrano, veterinarstvo in varstvo rastlin (UVHVVR) in Nacionalnega inštituta za javno zdravje (NIJZ) preiskujejo večje število okužb salmonele …
Maribor24 · 3L

Znane so podrobnosti večjega števila okužb na vzhodu države. Uprava za varno hrano, veterinarstvo in varstvo rastlin (UVHVVR) in Nacionalnega inštituta za javno zdravje (NIJZ) preiskujejo večje število okužb salmonele …
Maribor24 · 3L

Ševilo okuženih se je povečalo na 19, zadnja dva primera so zaznali v Ljubljani. Nacionalni inštitut za javno zdravje (NIJZ) skupaj z Upravo za varno hrano, veterinarstvo in varstvo rastlin …
Žurnal24 · 3L

Uprava za varno hrano, veterinarstvo in varstvo rastlin in NIJZ sta pojasnila prve rezultate preiskave več okužb s salmonelo, ki so jih zaznali v različnih delih Slovenije. Vzrok za okužbo …
RTV Slovenija · 3L

Okužbe so v zadnjih dneh zaznali predvsem v severovzhodnem delu države. Zaradi suma na prisotnost salmonele so v Lidlu odpoklicali tatarski biftek Fingušt. Uprava za varno hrano, veterinarstvo in varstvo …
Delo · 3L

Prva poročanja o okužbi s salmonelo prihajajo iz Murske Sobote. Vzhodna Slovenija beleži več primerov salmonel. Po do zdaj znanimi podatkih primere okužb obravnavajo območne enot NIJZ Ravne, Murska Sobota …
Maribor24 · 3L

Prva poročanja o okužbi s salmonelo prihajajo iz Murske Sobote. Vzhodna Slovenija beleži več primerov salmonel. Po do zdaj znanimi podatkih primere okužb obravnavajo območne enot NIJZ Ravne, Murska Sobota …
Maribor24 · 3L

V vzhodni Sloveniji so zaznali povečano število okužb s salmonelo. Do zdaj je potrjenih deset primerov, ki jih obravnavajo območne enot NIJZ Ravne, Murska Sobota in Celje. Vir okužbe v …
24ur · 3L

Proizvajalec stranke poziva, da zaradi možnega tveganja za zdravje izdelka ne uživajo. Trgovec Lidl je iz prodaje odpoklical Tatarski biftek Fingušt proizvajalca Mesnine Štajerske, in sicer zaradi suma na prisotnost …
Maribor24 · 3L

Trenutno potrjenih deset primerov. Epidemiološka preiskava je v teku. Nacionalni inštitut za javno zdravje skupaj z upravo za varno hrano preiskuje povečano število primerov salmoneloze v Sloveniji. Več informacij bodo …
Žurnal24 · 3L

NIJZ skupaj z upravo za varno hrano preiskuje povečano število primerov salmoneloze v Sloveniji. Več informacij bodo pristojne službe posredovale v sredo. Po dosedanjih podatkih je v vzhodni Sloveniji trenutno …
RTV Slovenija · 3L

Kot so zapisali na spletni strani Nacionalnega inštituta za javno zdravje (NIJZ), je bila epidemiološka služba NIJZ obveščena o povečanem številu prijavljenih salmoneloz, ki jih obravnavajo območne enote Ravne na …
Koroške novice · 3L

Nacionalni inštitut za javno zdravje skupaj z upravo za varno hrano preiskuje povečano število primerov salmoneloze v Sloveniji. Kot so zapisali na spletni strani Nacionalnega inštituta za javno zdravje (NIJZ), …
Maribor24 · 3L
Nacionalni inštitut za javno zdravje skupaj z upravo za varno hrano preiskuje povečano število primerov salmoneloze v Sloveniji. Več informacij bodo pristojne službe posredovale v sredo. Po dosedanjih podatkih je …
Regional · 3L
Nacionalni inštitut za javno zdravje skupaj z upravo za varno hrano preiskuje povečano število primerov salmoneloze v Sloveniji. Več informacij bodo pristojne službe posredovale v sredo. Po dosedanjih podatkih je …
Siol.net · 3L

Nacionalni inštitut za javno zdravje skupaj z Upravo za varno hrano, veterinarstvo in varstvo rastlin preiskuje povečano število primerov salmoneloze v Sloveniji. Do zdaj je potrjenih deset primerov, ki jih …
24ur · 3L

Nacionalni inštitut za javno zdravje skupaj z upravo za varno hrano preiskuje povečano število primerov salmoneloze v Sloveniji. Po dosedanjih podatkih je v vzhodni Sloveniji trenutno potrjenih deset primerov. Kot …
Svet24 · 3L

Zaradi okužbe s salmonelo naj bi v soboški bolnišnici sprejeli več pacientov. Je bil kriv biftek?
Mariborinfo · 3L